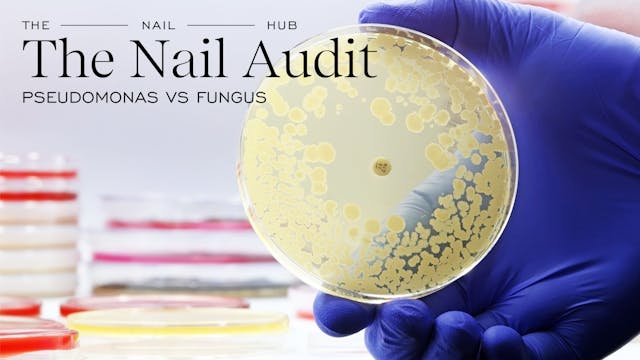

Live stream preview
Having trouble with gel shrinking back while you're applying it? Let's talk about receding gel and how to make sure you cap those free edges.
Up Next in The Nail Audit
-
Pseudomonas vs Fungus
Nail infections can come in many forms, and they are not fun to deal with. Let's look at a specific situation submitted by one of our members!
-
Cryptic SDS & Misleading Information
-
Working on Ridged Nails
Working over vertical depressions in the nail plate can cause some issues, especially when it comes to nail prep. Let's review how to work on these types of nail plates without causing damage.

13 Comments